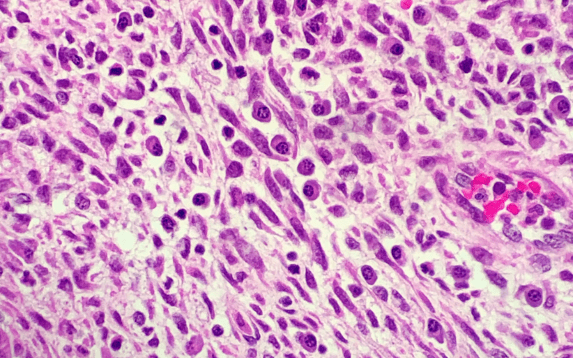
Chronic Endometritis Treatment in Palanpur

Quick Email Now!
-
-
Call Us
82380 16380 | 82380 15380
Quick Email Now!
Call Us

Chronic endometritis is a persistent inflammation of the uterine lining (endometrium) caused by infection or immune-related issues. It may not always cause noticeable symptoms but can silently affect fertility, implantation, and menstrual regularity. This condition often goes undetected in women facing repeated IVF failures or unexplained infertility. The inflammation disrupts the uterine environment, making it less receptive to embryo implantation.
The main causes of chronic endometritis include bacterial infections, retained tissue after miscarriage, intrauterine devices (IUDs), or prolonged uterine infections. Sometimes, immune system imbalance or untreated pelvic inflammation also contributes to the condition. Women with recurrent miscarriages, painful periods, or abnormal uterine bleeding are at higher risk. Identifying these causes early can prevent long-term reproductive complications and improve fertility outcomes.
Many women with chronic endometritis experience mild or no symptoms, which makes diagnosis challenging. However, common signs include irregular periods, pelvic pain, abnormal discharge, or spotting between cycles. In fertility cases, chronic endometritis can cause repeated implantation failure or early pregnancy loss. Recognizing these symptoms and consulting a fertility specialist promptly is crucial for timely treatment.
Accurate diagnosis is the first step toward effective treatment. At ISHA IVF & Fertility Center, doctors use advanced diagnostic tools such as endometrial biopsy, hysteroscopy, and microbial cultures to detect inflammation. Endometrial tissue analysis helps confirm the presence of plasma cells, the hallmark of chronic endometritis. Timely and precise diagnosis ensures targeted therapy and faster recovery.
Treatment typically involves antibiotics to eliminate infection and restore the normal uterine environment. In immune-related cases, additional therapies such as hormonal regulation or immune therapy may be recommended. Some women may benefit from fertility-enhancing treatments like intrauterine washing or IVF once the inflammation subsides. The goal is to create a healthy uterine lining ready for embryo implantation.
Untreated chronic endometritis can lead to recurrent pregnancy loss, IVF failure, or persistent menstrual irregularities. Early detection and appropriate therapy significantly improve the chances of natural conception or successful IVF outcomes. At ISHA IVF, doctors focus on comprehensive evaluation to ensure that the uterine lining heals completely before proceeding with fertility treatments.
The team at ISHA IVF & Fertility Center provides individualized treatment plans for women with chronic endometritis. Using modern diagnostic tools and evidence-based therapies, the experts ensure thorough care that restores reproductive health. From accurate testing to fertility planning, every step is guided by experience and compassion.
Expert guidance and emotional support at every step of your fertility journey.

Successful IVF Cases
Under the Expertise of Dr. Dhaval Dharani
ISHA IVF AND FETAL MEDICINE CENTRE, Aroma Circle, behind Hotel Cappal, Madhuvan Society, Nilkamal Society, Palanpur, Gujarat 385001, India
Copyright ©2026 Isha IVF . All Rights Reserved. Developed By i3 Corporation